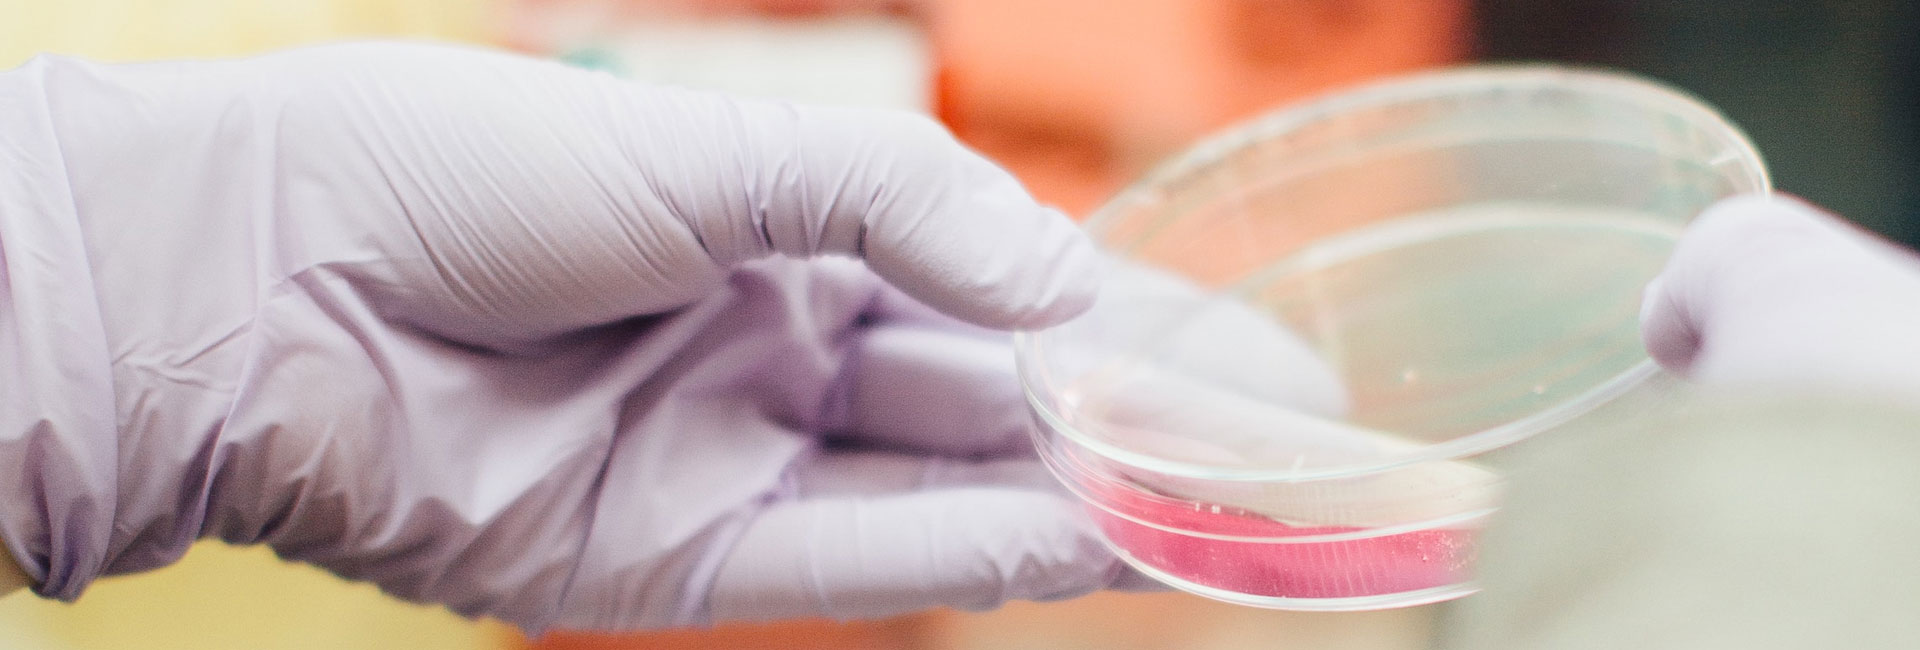

Our Customer Reviews
Amax user & supplier partners have acknowledged Amax Service and have complemented the support in below testimonials.We look forward to get associated with more user and supplier partners and work alongside them to establish a WIN-WIN PARTNERSHIP...!! Please feel free to reach us on sales@amaxadh.com

Mr. Amit, IOTA
Amax Adhesive India Pvt. Ltd. is a trusted and experienced company in the semiconductor and specialty chemical industry. They have a deep understanding of the market and the customer requirements. They offer high-quality products and services that are cos

Vaibhav, Motherson Invenza
We are very happy with Amax Adhesive India Pvt. Ltd. as our supplier and partner. They have a proven track record of delivering excellent products and services that match our expectations and goals. They are always ready to assist us with any queries or i

Rajender, Sapcon
Amax Adhesive India Pvt. Ltd. is a reputable and competent company in the semiconductor and specialty chemical industry. They have a comprehensive range of products and services that suit our requirements and budget. They are always prompt and professiona

Rajkumar, SKI
Amax Adhesive India Pvt. Ltd. is a leader in the semiconductor and specialty chemical industry. They have a strong team of engineers who can provide customized solutions and design support for our projects. They have a diverse portfolio of products and se

Ramesh, Minda Industries
Amax Adhesive India Pvt. Ltd. is a reliable and professional partner for our semiconductor needs. They have a wide range of products and services that meet our quality standards and specifications. We are very satisfied with their performance and support.

Pamkaj, Simpex
A reputable and competent company in the semiconductor and specialty chemical industry. They have a comprehensive range of products and services that suit our requirements and budget. They are always prompt and professional.

Vishal Kumar, Samvardhna motherson group
We have been working with Amax Adhesive India Pvt. Ltd. for over many years and we are impressed by their expertise and innovation. They have helped us to improve our processes and products with their cutting-edge solutions and design capabilities.

Arun, Titan Eye wear
Great company to work with. They have a wealth of knowledge and experience in the semiconductor and specialty chemical industry. They have a customer-oriented approach and a flexible attitude. They provide value-added products and services that enhance ou

Ravi, Auona
Remarkable company that offers innovative and quality products and services for the semiconductor and specialty chemical industry. They have a dedicated and skilled team of engineers who can handle any challenge or opportunity. They are always friendly an